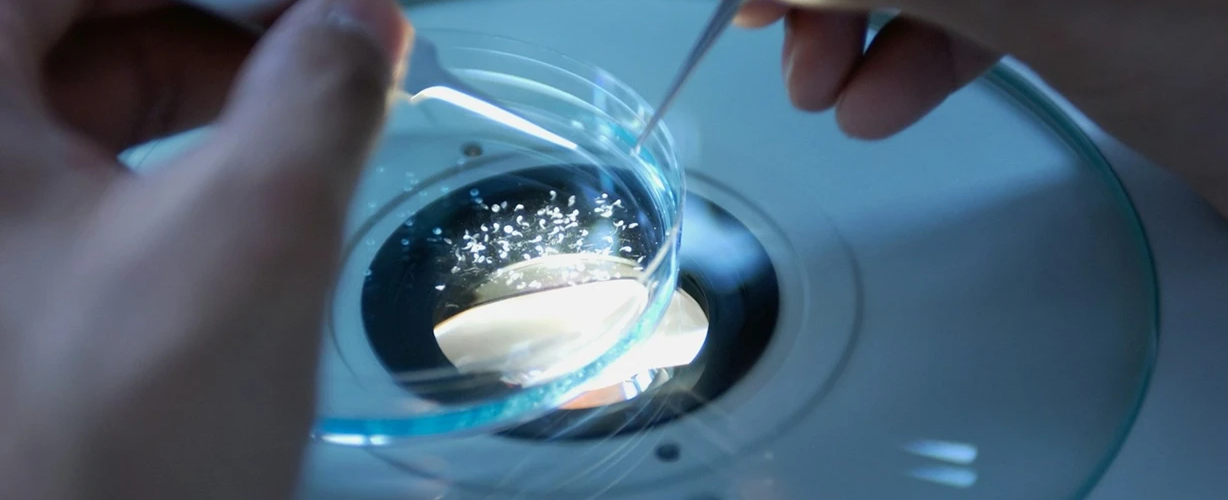
Bilim

Fizik, kimya, matematik, yaşam bilimleri ve mühendislik gibi disiplinler, temiz enerjiden dijital teknolojilere, sağlıktan iklim çözümlerine kadar birçok alanda inovasyonun ve başta iklim krizi olmak üzere birçok soruna karşı toplumların dayanıklılığını ve uyumunu artırmada başat bir rol oynuyor. 2025 yılı teması “Güven, dönüşüm ve yarın: 2050 için ihtiyaç duyduğumuz bilim” olarak belirlenen Barış ve Kalkınma için Dünya Bilim Günü’nde, sürdürülebilir kalkınma için önümüzdeki on yılların gereksinimlerini nasıl bir bilimin karşılayabileceği üzerine fikir alışverişinde bulunulacak.
Her yıl 10 Kasım tarihi olarak kabul edilen “Barış ve Kalkınma için Dünya Bilim Günü”, bilimin toplumdaki önemli rolünü ve ortaya çıkan bilimsel konular üzerine daha geniş bir kamuoyu katılımının gerekliliğini vurgulamayı amaçlıyor.
Bilim ve toplum arasındaki önemli bağlılık ilişkisine yönelik bir etkinlik düzenleme fikri, 1999 Budapeşte Dünya Bilim Konferansı’nın olumlu sonuçlarından biri olarak ortaya çıktı. UNESCO da 2001 yılında bu özel günün ilanından sonra, dünya genelinde bilime yönelik birçok somut proje ve program için finansman sağlamaya başladı.
Aynı çerçevede Ağustos 2023’te Birleşmiş Milletler (BM) Genel Kurulu, 2024–2033 dönemini “Sürdürülebilir Kalkınma için Bilim On Yılı” olarak ilan etti. Bu karar, bilimin dünyanın en acil sorunlarıyla mücadeledeki temel rolünü hatırlatmaya çalışırken girişim, 2030 Gündemi ve sonrasındaki hedeflere ulaşmanın yalnızca bilgi ve yenilikteki ilerlemelerle değil, aynı zamanda bilim, politika ve toplum arasındaki güçlü ortaklıklarla mümkün olacağını da kabul ediyor.
Nasıl Bir Bilime İhtiyacımız Var?
Gün kapsamında bilim insanlarının içinde yaşadığımız bu olağanüstü ama kırılgan gezegeni anlamamızı genişletmedeki ve toplumlarımızı daha sürdürülebilir hale getirmedeki rolleri vurgulanıyor.
Yanı sıra barışçıl ve sürdürülebilir toplumlar için bilimin rolüne dair kamuoyunun farkındalığını güçlendirmek, paylaşılan bilgi ve bilimsel işbirliği için ulusal ve uluslararası dayanışmayı teşvik etmek, toplumların yararına bilimin kullanılmasına yönelik ulusal ve uluslararası taahhütleri yenilemek ve bilimin karşılaştığı zorluklara dikkat çekmek de hedefler arasında yer alıyor. Ayrıca gün, çatışmalardan etkilenen bölgelerde yaşayan bilim insanları arasında işbirliğini teşvik etmeye de yardımcı olmaya çalışıyor.
Barış ve Kalkınma için Dünya Bilim Günü’nün 2025 teması ise “Güven, dönüşüm ve yarın: 2050 için ihtiyaç duyduğumuz bilim” olarak belirlendi. Tema kapsamında, sürdürülebilir kalkınma yolunda bir dünyanın önümüzdeki on yılların gereksinimlerini karşılamak için nasıl bir bilime ve bilim ile toplum arasında nasıl bir ilişkiye ihtiyaç duyulacağını masaya yatırmak amaçlanıyor.
Nitekim bu yolda, fizik, kimya, matematik, yaşam bilimleri ve mühendislik gibi disiplinler, temiz enerjiden dijital teknolojilere, sağlıktan iklim çözümlerine kadar birçok alanda inovasyonun ve başta iklim krizi olmak üzere birçok soruna karşı toplumların dayanıklılığını ve uyumunu artırmada başat bir rol oynuyor.
Tema bunu sağlamak adına işbirliğini geliştirmeye vurgu yaparak, bilimi herkes için erişilebilir kılmaya yönelik somut çözümler bulmaya odaklanıyor. Aynı zamanda küresel sorunlarla doğrudan mücadele edebilecek yeni nesil problem çözücülerin güçlenmesine de katkıda bulunmak hedefleniyor.